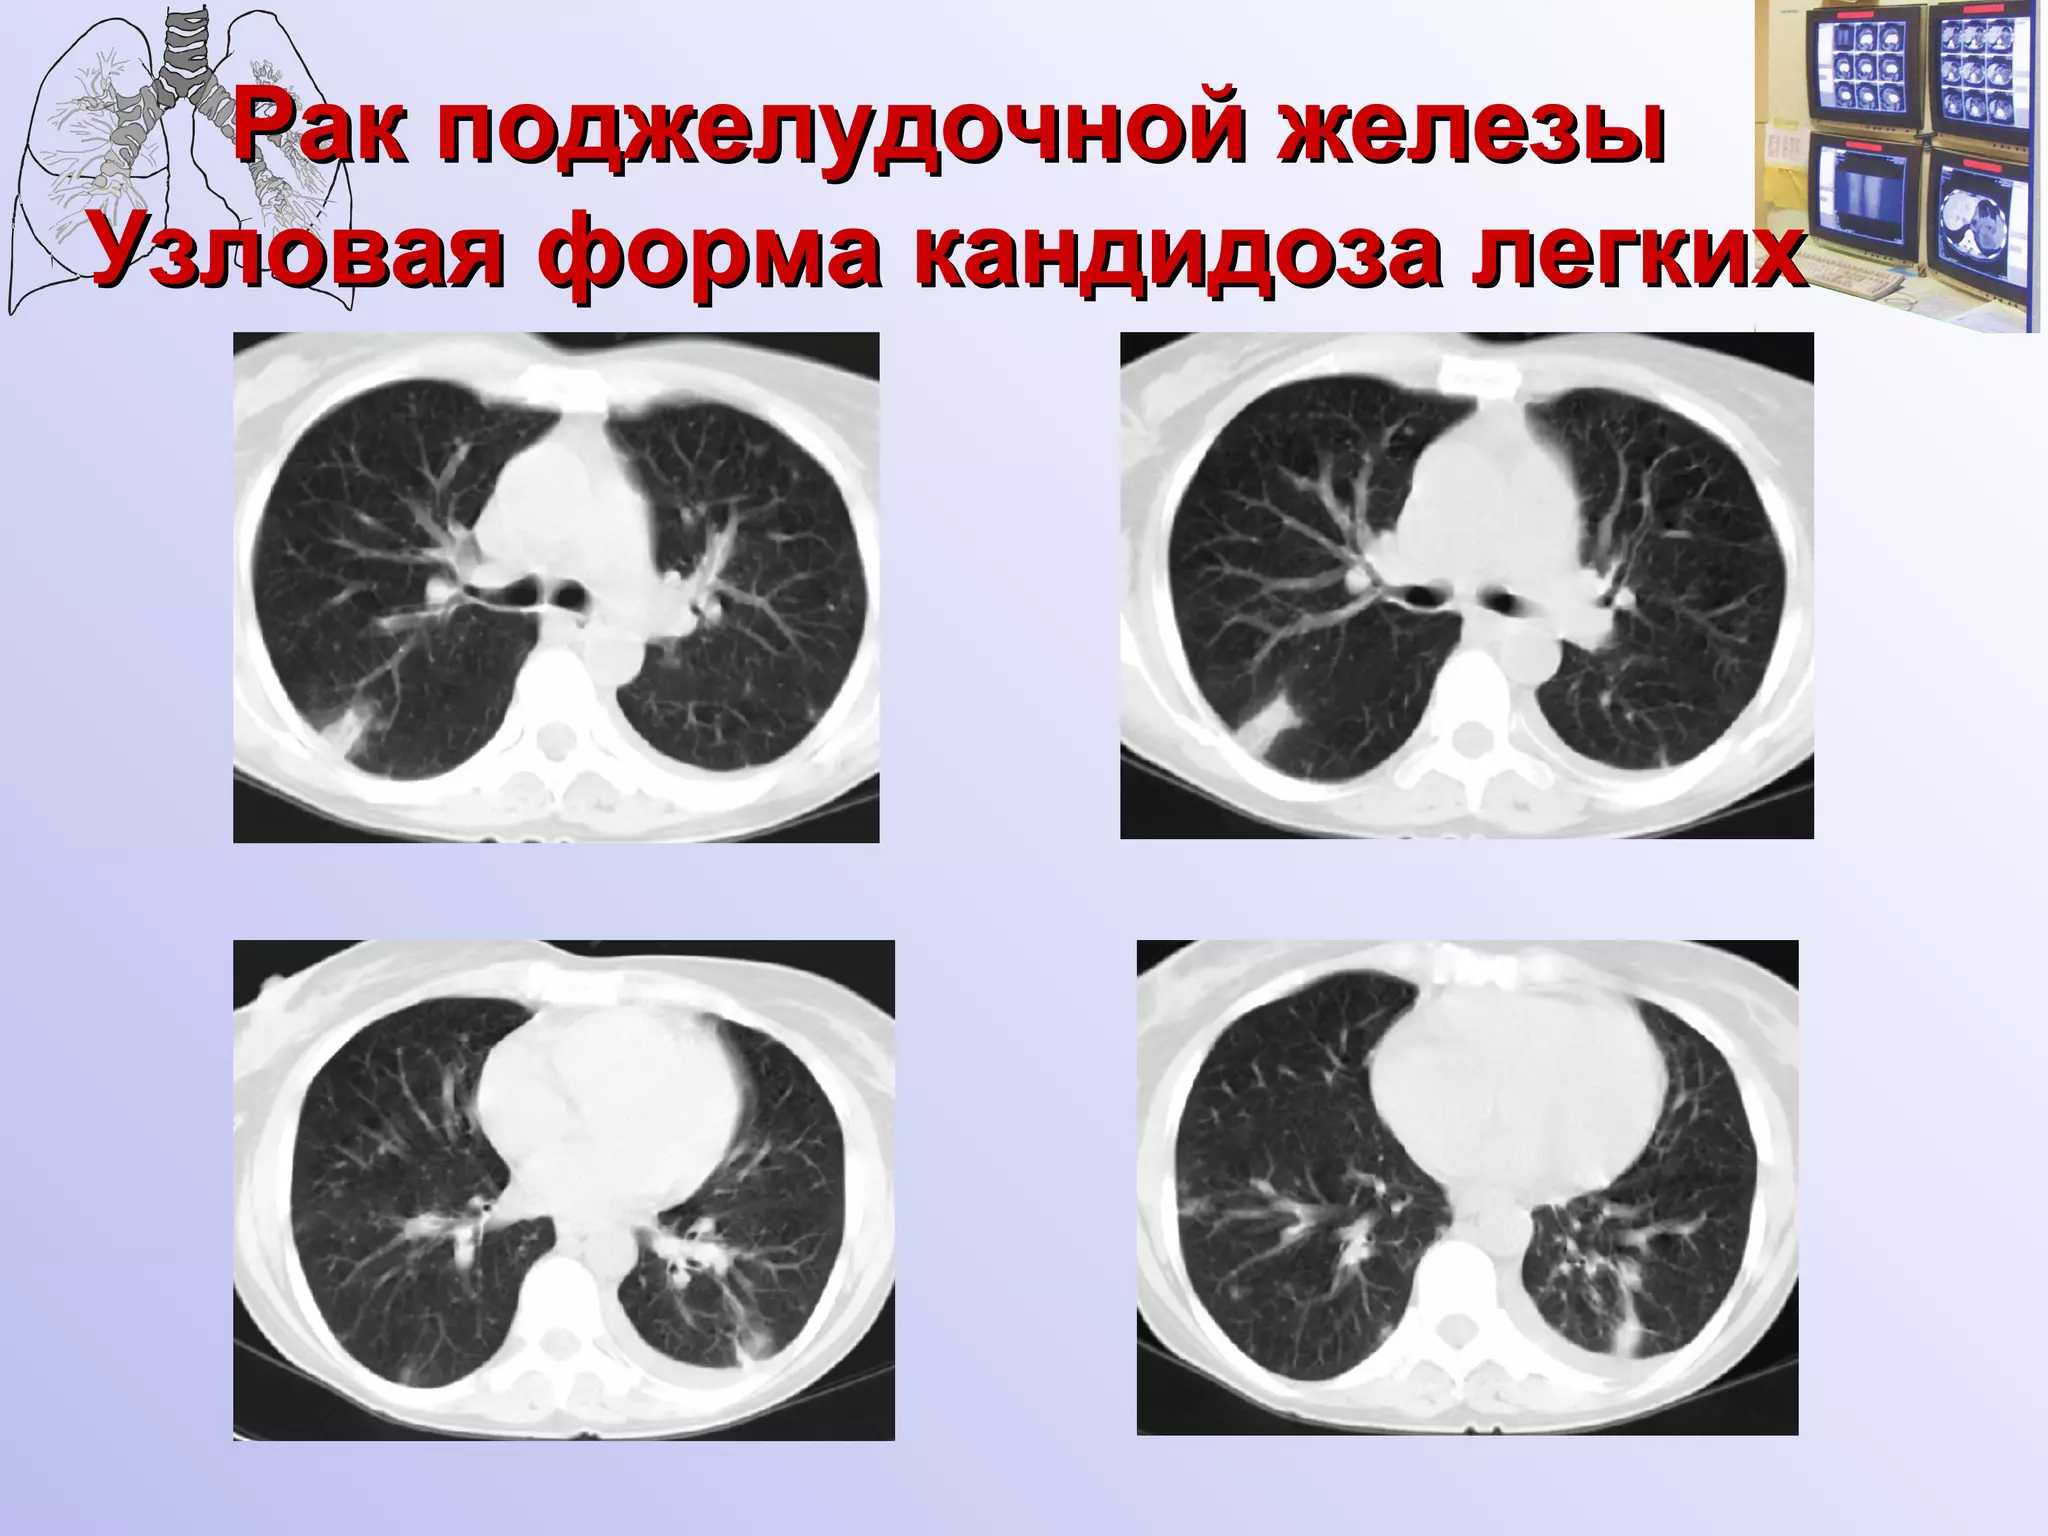
Рак поджелудочной железы   Узловая форма кандидоза легких

Документ описывает рентгенологические особенности нозокомеиальных микозов легких у онкологических больных, акцентируя внимание на различных патогенах, таких как грибы рода Aspergillus и Candida. Рассматриваются признаки и осложнения, связанные с прогрессированием основных заболеваний, а также специфическая рентгенологическая симптоматика. Важность правильной диагностики инфекционных процессов и возможные ошибки в интерпретации легочных изменений при онкологических заболеваниях также подчеркиваются.